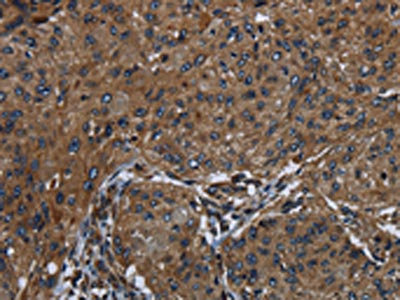

-
中文名稱:HOXC8兔多克隆抗體
-
貨號:CSB-PA091932
-
規格:¥1100
-
圖片:
-
The image on the left is immunohistochemistry of paraffin-embedded Human ovarian cancer tissue using CSB-PA091932(HOXC8 Antibody) at dilution 1/25, on the right is treated with synthetic peptide. (Original magnification: ×200)
-
The image on the left is immunohistochemistry of paraffin-embedded Human esophagus cancer tissue using CSB-PA091932(HOXC8 Antibody) at dilution 1/25, on the right is treated with synthetic peptide. (Original magnification: ×200)
-
Gel: 12%SDS-PAGE, Lysate: 40 μg, Lane: Human thyroid cancer tissue, Primary antibody: CSB-PA091932(HOXC8 Antibody) at dilution 1/200, Secondary antibody: Goat anti rabbit IgG at 1/8000 dilution, Exposure time: 10 seconds
-
-
其他:
產品詳情
-
Uniprot No.:
-
基因名:HOXC8
-
別名:Homeo box 3A antibody; Homeo box 8 antibody; Homeobox 3A antibody; Homeobox C8 antibody; Homeobox protein Hox C8 antibody; Homeobox protein Hox-3A antibody; Homeobox protein Hox-C8 antibody; Homeobox protein HoxC8 antibody; Homeobox protein R4 antibody; Homolog of mouse Hox 3.1 antibody; HOX 3 antibody; Hox 3.1 mouse homolog of antibody; HOX 3A antibody; HOX C8 antibody; Hox-3.1 antibody; Hox-3A antibody; HOX3 antibody; HOX3A antibody; HOXC 8 antibody; Hoxc-8 antibody; HOXC8 antibody; HXC8_HUMAN antibody; M31 antibody
-
宿主:Rabbit
-
反應種屬:Human,Mouse
-
免疫原:Synthetic peptide of Human HOXC8
-
免疫原種屬:Homo sapiens (Human)
-
標記方式:Non-conjugated
-
抗體亞型:IgG
-
純化方式:Antigen affinity purification
-
濃度:It differs from different batches. Please contact us to confirm it.
-
保存緩沖液:-20°C, pH7.4 PBS, 0.05% NaN3, 40% Glycerol
-
產品提供形式:Liquid
-
應用范圍:ELISA,WB,IHC
-
推薦稀釋比:
Application Recommended Dilution ELISA 1:2000-1:5000 WB 1:200-1:1000 IHC 1:50-1:200 -
Protocols:
-
儲存條件:Upon receipt, store at -20°C or -80°C. Avoid repeated freeze.
-
貨期:Basically, we can dispatch the products out in 1-3 working days after receiving your orders. Delivery time maybe differs from different purchasing way or location, please kindly consult your local distributors for specific delivery time.
-
用途:For Research Use Only. Not for use in diagnostic or therapeutic procedures.
相關產品
靶點詳情
-
功能:Sequence-specific transcription factor which is part of a developmental regulatory system that provides cells with specific positional identities on the anterior-posterior axis.
-
基因功能參考文獻:
- Results show that HOXC8 is consistently downregulated in stem/progenitor cells of all breast molecular subtypes, thus representing a putative tumor suppressor candidate. Also, downregulated expression of HOXC8 is associated with DNA methylation at the gene promoter and expression of miR196 family members. Taken together, study establishes HOXC8 as a suppressor of stemness and transformation in the mammary gland lineage. PMID: 28202042
- Owing to the overexpression of Homeobox C8 (HOXC8), findings implied that HOXC8 is involved in the progression of epithelial ovarian cancer (EOC) and could be a potential therapeutical approach of EOC. PMID: 26763553
- High expression of HOXC8 is associated with laryngeal squamous cell carcinoma. PMID: 27658780
- HOXC8 knockdown led to inhibition of tumor cell proliferation and migration in vitro by inhibiting MMP-9 expression and tumor growth in vivo. The results strongly suggest that HOXC8 is involved in the tumorigenesis of osteosarcoma and might serve as a novel predictor for patients' outcome. PMID: 27651160
- embigin is regulated by HOXC8 and its loss plays an important role in the progression of breast tumors PMID: 26090721
- Ectopic expression of HoxC8 inhibits nasopharyngeal carcinoma cell growth in vitro and in vivo, modulates glycolysis and regulates the expression of tricarboxylic acid (TCA) cycle-related genes. PMID: 25745994
- Upregulated HOXC8 expression was associated with oxaliplatin resistance in hepatocellular carcinoma. PMID: 26123838
- miR-196a was over-expressed in cervical cancer cells, while an absence of HOXC8 expression was observed. PMID: 24817935
- HOXC8 promotes breast tumorigenesis by transcriptionally facilitating cadherin-11 expression. PMID: 24810778
- HOXC8 can be used as a prognostic marker in esophageal squamous cell carcinoma PMID: 24525058
- HOXC8 expression is inversely related to pancreatic ductal adenocarcinoma progression and metastasis. PMID: 21712827
- a complex role for HOXC8 in prostate cancer, promoting invasiveness while inhibiting AR-mediated gene induction at androgen response element-regulated genes associated with differentiated function of the prostate PMID: 21047772
- Ratio of microRNA to HOXC8 mRNA may be an indicator of the metastatic capability of breast tumors. PMID: 20736365
- overexpression associated with loss of tumor differentiation in human prostate cancer; may play role in acquisition of invasive/metastatic phenotype PMID: 11813208
- Androgen-independent cell line DU145 cells lack PLZF gene expression, resulting in the upregulation of Pbx1 and HoxC8 expression. The Pbx1-HoxC8 heterocomplex may lead to androgen-independent growth in prostate cancer. PMID: 16637071
顯示更多
收起更多
-
亞細胞定位:Nucleus.
-
蛋白家族:Antp homeobox family
-
數據庫鏈接:
Most popular with customers
-
YWHAB Recombinant Monoclonal Antibody
Applications: ELISA, WB, IHC, IF, FC
Species Reactivity: Human, Mouse, Rat
-
Phospho-YAP1 (S127) Recombinant Monoclonal Antibody
Applications: ELISA, WB, IHC
Species Reactivity: Human
-
-
-
-
-
-